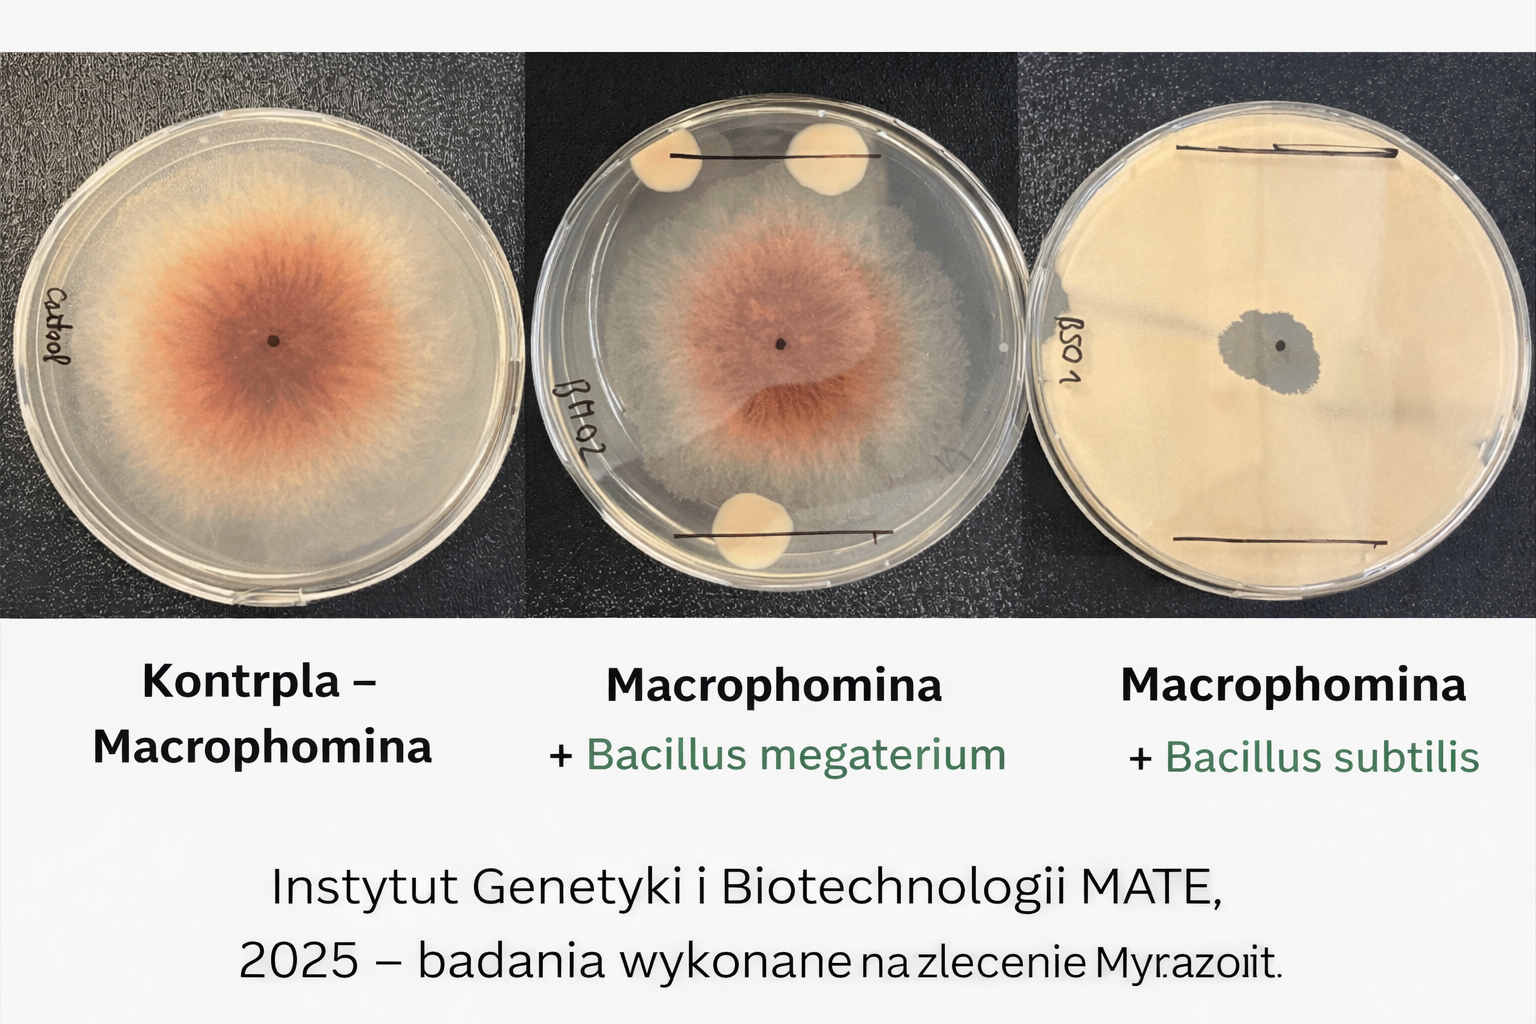

Biologia gleby oparta na badaniach i danych
Współczesne rolnictwo nie opiera się już wyłącznie na rutynie, lecz na świadomych i odpowiedzialnych decyzjach technologicznych. Zmiany klimatyczne, rosnąca presja patogenów oraz duża zmienność kosztów środków produkcji sprawiają, że gospodarstwa muszą opierać swoje strategie produkcyjne na sprawdzonych, naukowo potwierdzonych rozwiązaniach.
Coraz większą rolę odgrywają technologie, które nie tylko reagują na pojawiające się problemy, ale przede wszystkim zapobiegają ich powstawaniu poprzez wzmacnianie gleby i roślin.
Nowoczesne rozwiązania mikrobiologiczne powstają w oparciu o badania laboratoryjne, doświadczenia polowe oraz analizę procesów zachodzących w glebie. Dzięki temu możliwe jest opracowywanie technologii, które wspierają naturalne mechanizmy biologiczne gleby i poprawiają warunki wzrostu roślin.

Nauka i praktyka w służbie rolnictwa
W rozwoju technologii biologicznych ogromną rolę odgrywają badania mikrobiologiczne oraz eksperymenty prowadzone w warunkach laboratoryjnych i polowych. Obejmują one m.in.:
-
analizy mikrobiologiczne gleby
-
doświadczenia laboratoryjne z udziałem bakterii glebowych
-
doświadczenia polowe w różnych warunkach środowiskowych
-
szczegółową analizę wyników i procesów biologicznych
Celem takich badań jest nie tylko poznanie funkcjonowania mikroorganizmów glebowych, ale przede wszystkim opracowanie praktycznych technologii wspierających produkcję roślinną.
Dzięki temu rozwiązania mikrobiologiczne mogą być stosowane w sposób świadomy i dopasowany do warunków gospodarstwa.
Innowacje wspierające nowoczesne gospodarstwa
Rozwój biologicznych technologii uprawy roślin obejmuje również narzędzia umożliwiające dokładniejszą analizę gleby i procesów w niej zachodzących.
Jednym z przykładów takich rozwiązań są systemy diagnostyczne oparte na skanowaniu gleby, które pozwalają na prowadzenie analiz w sposób precyzyjny i lokalnie dopasowany do warunków pola. Dzięki temu możliwe jest podejmowanie decyzji technologicznych w oparciu o konkretne dane dotyczące gleby i jej aktywności biologicznej.
Równolegle rozwijane są także mikrobiologiczne rozwiązania dedykowane konkretnym uprawom, które wspierają rozwój roślin oraz poprawiają ich odporność na stres środowiskowy.

Znaczenie biologicznej ochrony przed patogenami
Jednym z najważniejszych wyzwań współczesnego rolnictwa jest rosnąca presja chorób odglebowych. W ostatnich latach szczególną uwagę zwraca patogen Macrophomina, który w wielu regionach powoduje poważne straty w uprawach.
Dlatego coraz większe znaczenie ma profilaktyczne podejście oparte na biologii gleby, którego celem jest wzmacnianie roślin i ograniczanie rozwoju patogenów już na etapie wczesnego rozwoju systemu korzeniowego.
Co pokazują badania laboratoryjne?
Podczas badań laboratoryjnych przeprowadzono doświadczenia w płytkach Petriego, analizując wpływ różnych szczepów bakterii na rozwój patogenicznych grzybów.
W pierwszej płytce badawczej znajdował się wyłącznie patogen grzybowy. Jego swobodny rozwój odzwierciedla naturalny przebieg infekcji w glebie.
W drugiej płytce do patogenu dodano szczep bakterii, który nie wykazuje działania przeciwgrzybowego. W tym przypadku rozwój grzyba również przebiegał bez większych ograniczeń.
W trzecim wariancie badania zastosowano szczep Bacillus subtilis, znany ze swoich właściwości antagonistycznych wobec patogenów. W tym przypadku obserwowano zatrzymanie wzrostu grzyba oraz powstanie wyraźnych stref ochronnych, w których rozwój patogenu został zahamowany.
Biologia gleby jako element bezpieczeństwa produkcji
Wyniki takich badań pokazują wyraźnie, że mikroorganizmy glebowe mogą odgrywać istotną rolę w ograniczaniu presji patogenów. Wspieranie życia biologicznego gleby nie jest jedynie koncepcją teoretyczną, lecz procesem, który można obserwować i mierzyć.
Odpowiednio dobrane rozwiązania mikrobiologiczne pozwalają:
-
wspierać naturalne procesy biologiczne gleby
-
ograniczać rozwój niektórych patogenów
-
poprawiać kondycję systemu korzeniowego roślin
-
zwiększać stabilność produkcji w zmiennych warunkach środowiskowych
Dlatego coraz więcej gospodarstw traktuje biologię gleby jako jeden z kluczowych elementów nowoczesnej technologii produkcji roślinnej.





